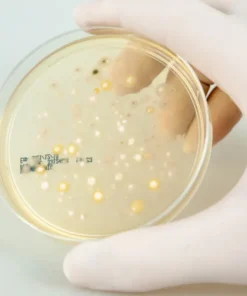

Mô tả:
Máy đếm hạt PCE-AS1 là máy đo lấy mẫu không khí dùng để đánh giá ô nhiễm vi sinh và giám sát vệ sinh. Được thiết kế để sử dụng trong bệnh viện, phòng sạch và các cơ sở sản xuất thực phẩm, đồ uống, mỹ phẩm và dược phẩm, Máy đếm hạt PCE-AS1 đáp ứng các yêu cầu mới nhất đối với các thiết bị dùng để phân tích vi khuẩn trong không khí. Chứng chỉ phòng thí nghiệm hiệu chuẩn ISO tùy chọn làm phụ kiện.
Máy đếm hạt PCE-AS1 sử dụng nguyên lý tác động của khí dung hoặc nguyên lý va chạm Andersen để đánh giá chất lượng không khí. Không khí được đưa vào ở phía trên của thiết bị được kéo qua 300 micropores và luồng không khí thành từng lớp được dẫn lên bề mặt của đĩa thạch petri. Khi chu trình lấy mẫu hoàn tất, đĩa petri được lấy ra và ủ. Sau đó, số lượng vi khuẩn và nấm có thể được đánh giá theo hướng dẫn USP 797 và CAG-009.
Đầu thu phải được khử trùng trong nồi hấp ở 121° C trong 30 phút (cũng có thể khử trùng bằng vải có cồn 75%.) Đĩa petri cũng phải được khử trùng bằng cồn 75%.

Thông số kỹ thuật:
– Màn hình LCD có đèn nền
– Bộ nhớ lên tới 99 thông số
– Đầu thu thập có thể khử trùng
– Thể tích có thể điều chỉnh lên tới 6000 l
– Pin mạnh
– Sử dụng đĩa petri tiêu chuẩn
| Số lượng vi lỗ trong đầu thu | 589 |
| Đường kính lỗ của micropores | 0,8 mm / 0,03″ |
| Ắc quy | 6400 mA |
| Thông lượng mẫu | 100 lít mỗi phút (l/phút) hoặc 3,53 feet khối mỗi phút |
| Tốc độ dòng chảy ở đầu đo | 0,38 l/phút |
| Tự động điều khiển khối lượng đo | 10 … 6000 lít |
| Kích thước của tấm | ø 70 … 90 x 15 mm / ø 2,76 x 3,54 x 0,59 inch |
| Lưu trữ dữ liệu | tối đa. 99 thông số và 2000 giá trị đo |
| Kích thước | ø 120 x 300 mm / ø 4,72 x 11,81 inch |
| Tiêu chuẩn | ISO 14698-1 |
| Cân nặng | 2,6 kg / 5,73 lb |

Đánh giá
Chưa có đánh giá nào.